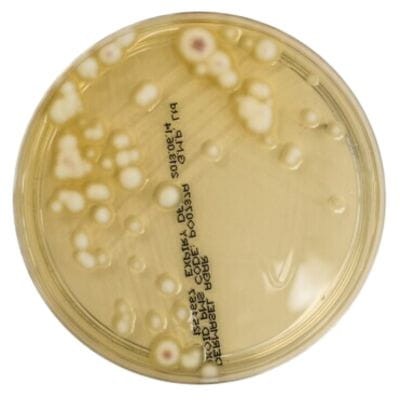
Dermasel_Selective_Medium_gotowa_pożywka_na_płytkach_Bestlabs.jpg

Dermasel Selective Medium gotowa pożywka na płytkach do izolacji grzybów dermatofitowych
• Opakowanie: 10 szt.
• Płytka: 90 mm.
• Do izolacji grzybów dermatofitowych.
• Wyrób medyczny: Tak.
 Opis
Opis
Dermasel Selective Medium – gotowa pożywka na płytkach do izolacji grzybów dermatofitowych
Dermasel Selective Medium to wysokiej jakości podłoże mikrobiologiczne opracowane specjalnie do izolacji i identyfikacji grzybów dermatofitowych z próbek biologicznych, takich jak zeskrobiny włosów, paznokci czy skóry. Gotowe do użycia płytki ułatwiają przeprowadzenie szybkich i dokładnych badań w laboratoriach mikrobiologicznych.
Zastosowanie Dermasel Selective Medium
Izolacja i identyfikacja dermatofitów
Podłoże Dermasel Agar zapewnia selektywne warunki do hodowli dermatofitów, które można łatwo rozpoznać dzięki ich charakterystycznej morfologii kolonialnej oraz typowej pigmentacji. To niezastąpione narzędzie w badaniach diagnostycznych infekcji grzybiczych skóry, paznokci i skóry głowy.
Zastosowanie w laboratoriach mikrobiologicznych
Produkt jest przeznaczony do zastosowań diagnostycznych w placówkach medycznych, laboratoriach badawczych oraz instytucjach naukowych, które specjalizują się w badaniach grzybów dermatofitowych.
Specyfikacja produktu
Podstawowe informacje
- Opakowanie: 10 sztuk gotowych do użycia płytek.
- Średnica płytki: 90 mm.
- Zastosowanie: Izolacja i identyfikacja grzybów dermatofitowych.
Cechy podłoża Dermasel Selective Medium
- Neutralne pH: Wspiera optymalny rozwój dermatofitów.
- Cykloheksymid: Hamuje rozwój grzybów saprofitycznych i drożdży, eliminując konkurencyjne mikroorganizmy.
- Charakterystyczna pigmentacja kolonii: Ułatwia identyfikację dermatofitów na podstawie ich cech morfologicznych.
Cechy i zalety produktu
1. Selektywność i precyzja diagnostyczna
Podłoże zostało opracowane tak, aby skutecznie wspierać wzrost dermatofitów, jednocześnie eliminując rozwój flory bakteryjnej oraz innych grzybów saprofitycznych. Dzięki temu wyniki badań są precyzyjne i wiarygodne.
2. Łatwość identyfikacji dermatofitów
Dermatofity hodowane na podłożu Dermasel Agar wykazują charakterystyczną morfologię kolonialną, która w połączeniu z typową pigmentacją pozwala na ich szybką identyfikację. Dodatkowe badanie mikroskopowe makrokonidiów i mikrokonidiów potwierdza diagnozę.
3. Gotowość do użycia
Produkt jest dostępny w formie gotowych płytek, co eliminuje konieczność samodzielnego przygotowywania podłoża w laboratorium. To oszczędność czasu i redukcja ryzyka błędów podczas przygotowywania.
4. Uniwersalność zastosowań
Podłoże jest odpowiednie do izolacji dermatofitów zarówno z próbek medycznych (np. zeskrobin skóry, paznokci), jak i z próbek środowiskowych, gdzie możliwe jest występowanie tych grzybów.
Instrukcja stosowania Dermasel Selective Medium
Przygotowanie i siew próbek
- W warunkach aseptycznych otwórz opakowanie z płytkami.
- Pobierz próbkę biologiczną, np. zeskrobinę skóry, włosów lub paznokci.
- Posiej próbkę na powierzchnię podłoża, stosując odpowiednią technikę mikrobiologiczną.
Inkubacja
- Inkubuj płytki w temperaturze 25°C ± 2°C przez okres od 4 do 7 dni, w zależności od rodzaju próbki.
Interpretacja wyników
- Kolonie dermatofitów: Typowa morfologia kolonialna i pigmentacja.
- Obecność innych mikroorganizmów: Hamowana dzięki zastosowaniu cykloheksymidu.
Dlaczego warto wybrać Dermasel Selective Medium?
- Wysoka jakość i niezawodność: Produkt testowany zgodnie z najwyższymi standardami mikrobiologicznymi, co gwarantuje rzetelne wyniki badań.
- Selektywne działanie: Specjalna formuła podłoża eliminuje wpływ innych mikroorganizmów, co pozwala skupić się na analizie dermatofitów.
- Łatwość stosowania: Gotowe płytki są wygodne w użyciu, co zwiększa efektywność pracy w laboratorium.
- Uniwersalność: Idealne do badań próbek medycznych i środowiskowych w diagnostyce dermatofitów.
Podsumowanie
Dermasel Selective Medium to niezastąpione narzędzie w izolacji i identyfikacji dermatofitów. Dzięki swojej selektywnej formule, łatwości użycia oraz możliwości szybkiej identyfikacji charakterystycznych kolonii, podłoże spełnia najwyższe wymagania diagnostyki mikrobiologicznej.
__________________________________________________________________________________________________________________________________________________________________________________________
Jest to wyrób medyczny.
Wyrób medyczny przeznaczony wyłącznie do użytku profesjonalnego, zgodnie z definicją zawartą w art. 2 pkt 1.26 Ustawy o wyrobach medycznych. Produkty te nie są przeznaczone do stosowania w warunkach domowych. Zakupu mogą dokonać jedynie osoby posiadające Prawo Wykonywania Zawodu (PWZ) lub firmy, podając numer NIP podczas składania zamówienia. W przypadku zamówienia złożonego przez użytkownika domowego, zostanie ono anulowane, a ewentualna wpłata zwrócona na konto klienta.
__________________________________________________________________________________________________________________________________________________________________________________________
W powyższym linku znajdą Państwo bazę aktualnych certyfikatów firmy OXOID. Wystarczy wpisać numer LOT zamówionej przez Państwa partii, w celu uzyskania odpowiedniego certyfikatu.
 Koszty dostawy
Cena netto, nie zawiera podatku
Koszty dostawy
Cena netto, nie zawiera podatku
darmowa i wygodna wysyłka
już od 800 zł netto
Najwyższa jakość
produktów potwierdzona certyfikatami
Zakupy 24h na dobę
wygodne i bezpieczne
bezpłatna konsultacja
z ekspertem online